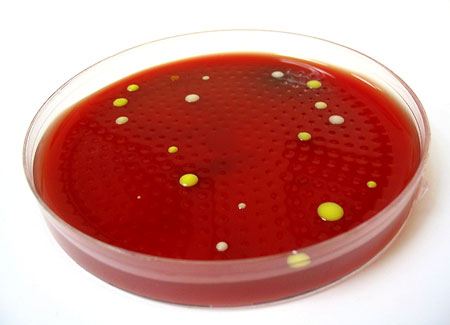

Hello Hello,
I hope you are enjoying the new year. What follows is an article about bacterial sampling by Tharanga Abeysekera and another about the bacterium Legionella by Dr. Michelle Seidl. I hope you'll find both articles interesting and helpful.
With best wishes,
Dave Gallup
Bacteria – A General Overview on Sampling
By Tharanga Abeysekera, EMLab™ Analyst
Bacteria were first discovered by Anton van Leeuwenhoek in 1674 using a single lens microscope. Since then, they have been found in every habitat on the planet such as water, soil, air, hot springs, very acidic environments and even on human skin. Bacterial cells are prokaryotes so they do not contain a nucleus or other membrane bound organelles. Cells range in size from 0.5 micrometers to 0.5 millimeters in length. There are three types of bacterial cells; spherical (e.g. Staphylococcus, Micrococcus), rod shaped (e.g. Bacillus, Pseudomonas) and spiral (e.g. Vibrio). Bacterial organisms differ in their cell shapes, metabolic pathways, growth requirements, Gram stains, and biochemical reactions from each other. Many bacterial organisms can be cultured in the laboratory using nutrient agars and appropriate temperatures. Once grown in the laboratory their differentiating characteristics can be used to identify them. The new methods that are used to identify bacterial organisms are DNA, PCR and Fatty acid testing.
Most people think of bacteria as disease causing organisms. However, they perform a very important role in every habitat. For example, they process dead organic materials. They are essential to normal life and play an important role in digestion and other functions in the human body. They also produce some common food products, such as vinegar, cheese and yogurt. Humans use certain bacterial organisms as indicators to assess the degrees of contamination. For example, E. coli and Enterococcus are used as indicators of sewage contamination. Total Coliform is used for drinking water standards.
That being said, some bacteria do cause disease. Some bacterial diseases are Cholera, Tuberculosis, and Legionnaires disease. Most bacterial species can be opportunistic pathogens and these can be treated with antibiotics. The most common bacterial infections are caused by Staphylococcus aureus.
Bacteria are present in all indoor/outdoor environments. Many wonder what is an acceptable level of bacteria in an indoor environment but no formal limits have been established for air and surface bacterial samples. The most common air sampling methods use an Anderson, BioCassette, or SAS sampler. The normal sampling time is 3-5 minutes. The most common media used are TSA with blood, MacConkey agar and R2A. In the absence of formal limits a mixture of bacteria with no predominating colony is considered normal air flora for most environments. The most common bacterial types found in an indoor air sample are Micrococcus, Staphylococcus, Corynebacterium and Gram negative non-fermenters. It is very common to find higher levels of bacteria inside than outside due to human activity.
Air sample from indoor environment
Copyright © 2007 Environmental Microbiology Laboratory, Inc.
Surface samples are normally taken using sterile swabs, wipes, dust cassettes or as bulk samples. It is very hard to establish formal limits for surface samples because all surfaces are not the same. Many inside surface samples will contain high bacterial counts due to human activity and skin cells.
In the absence of standards, a mixture of Gram positives (cocci and rods) is considered normal for normal office and residential environments. Most common Gram positive cocci found on a surface samples are skin organisms such as Microccocus and Staphylococcus. The common Gram positive rods found on surface samples are Corynebacterium and Bacillus. A mixture of all these organisms is considered normal even if high counts are present. Things to look out for are high counts of Gram negative non-fermenters which indicate high levels of moisture and high counts of E. coli which generally indicate sewage contamination. A control sample should be taken from an uncontaminated area for comparison. This will help with the interpretation of data. Most samples should be sent overnight to the laboratory to minimize changes in the bacterial population during shipping. Swab and wipe samples should contain a transport medium like Amies liquid (buffer). This will prevent the samples drying out and killing the bacteria.
Potable water samples are routinely checked for bacterial contaminants like Total Colifom, Fecal Coliform, E. coli and Legionella. Potable water samples should contain a preservative, such as sodium thiosulfate, to neutralize the chlorine. Non-potable water samples (cooling towers) are routinely tested for Legionella. All non-regulatory water samples should be shipped to the laboratory within 24 hours of sampling.
Reference:
Wikipedia: Bacteria
Microorganism of the Month: Legionella
By Dr. Michelle Seidl, EMLab™ Analyst
Legionella is an aerobic, Gram-negative, rod-shaped bacterium genus. It includes species that cause the disease legionellosis. Two forms of legionellosis are known as Legionnaires' disease and Pontiac fever. Legionella bacteria are found in water sources within the environment and can exist as facultative (optional) parasites. When parasitic, their host is a protozoan in the Kingdom Protista, i.e. amoebae. Legionella grows best in warm, stagnant water, like the kind found in hot tubs, cooling towers, hot water tanks, large plumbing systems or air conditioning systems in large buildings. Generally, Legionella is associated with poorly maintained cooling towers, potable water systems or a warm water system that disseminates water particularly as aerosols, sprays or mists. In the natural environment, Legionella is present in low levels in lakes, streams, rivers, freshwater ponds, and mud. However, the levels found in the natural environment are so low that it is unlikely that an individual will contract the disease from these sources. The risk of exposure increases when high concentrations of the organism grow in water systems.
Legionella colonies are 3 to 4 mm in diameter, grayish white to bluish green, shiny, convex and circular. Some species will fluoresce bright white or red with ultraviolet light, which can be useful in differentiating species. Each bacterium is cylindrical or rod-shaped, measuring 0.5-1.0 micrometers wide by 1.0-3.0 micrometers in length (Barbaree 1991). The complete circular Legionella pneumophila genome has recently been sequenced and consists of 3,397,754 base pairs.
Legionella and legionellosis were named in 1977, when attendees of a 1976 American Legion convention in Philadelphia were affected by an outbreak of a previously unnamed bacterium, causing a type of pneumonia resulting in 34 deaths. Legionella pneumophila was the cause of the outbreak and undoubtedly had caused previous outbreaks of pneumonia, but the slowness of growth and special growth requirements prevented earlier discovery. Since that time, many detection methods have been discovered and it is now estimated that each year in the United States between 10,000 and 50,000 cases of Legionnaires' disease are reported (www.osha.gov). The disease is more commonly reported in the summer and early fall, but reports have been noted throughout the year. Other species of Legionella can cause legionellosis, but the majority of cases are caused by L. pneumophila. This bacterium exists in a number of distinguishable serogroups, which are closely related groups that share common, measurable surface components. Each serogroup of L. pneumophila contains further subtypes that have different surface structures on the cell membrane and can be distinguished by certain tests.

Legionella on contact plate.
Copyright © 2007 Environmental Microbiology Laboratory, Inc.
Legionellosis is a bacterial disease commonly associated with water-based aerosols that originate from warm water sources. Disease transmission is most likely to occur via inhalation of aerosols, fine sprays, mists or other microscopic contaminated water droplets, providing direct access into the lungs. Aspiration is another route whereby Legionella could potentially enter the respiratory tract and lungs. There is no evidence for person-to-person transmission.
Legionnaires' disease is characterized by fever, myalgia, cough and pneumonia. The incubation period (the time from exposure to onset of symptoms) is 2 to 10 days. Early symptoms may include fever, headache, achiness, tiredness and loss of appetite. Later symptoms include high fever, cough, difficulty breathing, shortness of breath, chills, chest pain and common gastrointestinal upset. Not all individuals with Legionnaires' disease experience the same symptoms. Pontiac fever is a milder illness without pneumonia and a shorter incubation period (1 to 3 days). This disease produces flu-like symptoms that may include fever, headache, tiredness, loss of appetite, achiness, chills, nausea and a dry cough. No deaths from Pontiac fever have been reported and full recovery usually occurs in two to five days without medical intervention.
Samples for Legionella analysis usually arrive in the form of potable water, non-potable water and swabs. Samples are analyzed for Legionella by culture on special media requiring up to 2 weeks for complete growth, isolation and analysis. Additional methods used include latex agglutination, direct fluorescence antibody test and PCR (polymerase chain reaction) DNA amplification. The PCR method is relatively new and further testing is needed before this technique can be accepted as the method of choice for monitoring water sources.
References:
1. Forbes, Betty A., Daniel F. Sahm, Alice S. Weissfeld; photography by Ernest A. Trevino. 1998. Bailey & Scott's Diagnostic Microbiology. St. Louis, MO: Mosby.
2. Barbaree, J. M. 1991. Controlling Legionella in cooling towers. ASHRAE Journal, June, pages 38-42.
3. University of Florida: Medical Informatics
4. OSHA